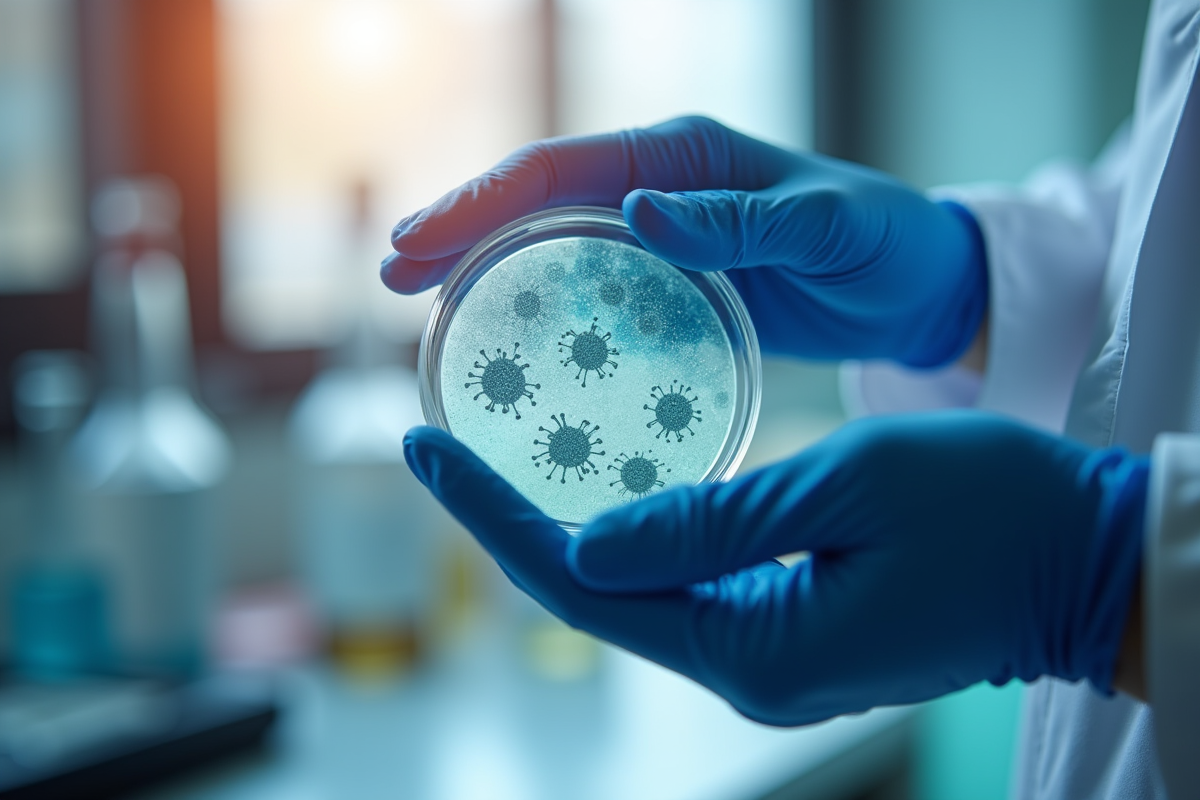

Le variant Nimbus ne respecte pas les scénarios écrits à l’avance : il a surgi là où on ne l’attendait pas, affichant une mutation inédite sur la protéine Spike, repérée au tout début du mois de mars 2025 dans trois pays européens. De son côté, Stratus, repéré simultanément en Asie, démontre une capacité à échapper au système immunitaire qui dépasse celle des variantes précédentes. Déjà, les premiers relevés signalent une hausse de transmission dans plusieurs zones. Pour le moment, l’afflux dans les hôpitaux reste contenu.En réaction, les autorités sanitaires ont ajusté, dès le 8 avril, les recommandations sur les rappels vaccinaux, en tenant compte de ces deux souches émergentes. Les premières comparaisons avec les anciens géants Delta et Omicron font apparaître des différences frappantes, tant sur la vitesse de diffusion que sur la manière dont ces nouveaux variants résistent aux traitements existants.
Où en est la circulation des variants de la COVID-19 en avril 2025 ?
En avril 2025, la circulation des variants de la COVID dessine une géographie en mosaïque. Les données publiées par l’Organisation mondiale de la santé (OMS) révèlent une recrudescence de la transmission dans certains pays d’Europe occidentale. Ailleurs, l’incidence reste nettement plus basse. En France, le dernier rapport de Santé publique France le confirme : Nimbus s’impose en force. Près de 60 % des séquences analysées au cours des deux dernières semaines lui sont attribuées.
A découvrir également : Les maladies majeures qui façonneront la santé en 2025
La surveillance virologique, à l’échelle mondiale, suit de près la naissance de nouveaux lignages, souvent simultanément sur différents continents. Pour mieux comprendre la situation actuelle, ce tableau synthétise la répartition des variants dans les grandes régions au 10 avril :
| Région | Variant dominant | Tendance |
|---|---|---|
| Europe | Nimbus | En hausse |
| Asie | Stratus | Stable |
| Amériques | Omicron BA. 2 | Légère baisse |
Le risque épidémique reste sous surveillance rapprochée : l’OMS n’observe pas de détérioration globale de la gravité de la maladie à l’échelle mondiale, bien que la diffusion de Nimbus s’accélère. En France, les autorités sanitaires invitent à adapter les mesures en fonction de la dynamique locale et à rester attentif aux signaux émergents. D’un pays à l’autre, la circulation du virus évolue, révélant une dynamique qui réserve encore bien des surprises.
A découvrir également : Pourquoi la reprogrammation du cerveau transforme votre quotidien
Nimbus et Stratus : ce que l’on sait des nouveaux variants
Depuis sa première apparition à Lyon en janvier 2025, le variant Nimbus a rapidement conquis du terrain, suivi à la trace par les équipes du centre national de référence. Les séquençages du SARS-CoV-2 mettent en lumière plusieurs mutations inédites sur la protéine Spike, en particulier sur les sites d’attachement à l’ACE2. Conséquence directe : la contagiosité grimpe, tout comme la capacité du virus à contourner, au moins partiellement, les défenses immunitaires acquises après une infection ou une vaccination.
Stratus, lui, intrigue les chercheurs par son patrimoine génétique atypique. D’abord repéré en Europe centrale, il porte des mutations sur le gène Nsp6 et la région Orf8. Les virologues lyonnais soulignent la nécessité de renforcer la surveillance, car ni son ampleur ni sa transmissibilité ne sont encore totalement cernées. À ce stade, on n’a pas constaté de modification majeure du tropisme cellulaire, mais la prudence reste la règle, faute de recul suffisant.
Pour résumer les points distinctifs de ces deux variants, les équipes de veille mettent en avant :
- Nimbus : progression rapide, mutations sur Spike, capacité à échapper partiellement à l’immunité.
- Stratus : mutations sur Nsp6 et Orf8, diffusion encore restreinte, profil étroitement surveillé.
Semaine après semaine, les équipes de veille analysent l’évolution de ces variants SARS-CoV-2, en s’appuyant sur les données des hôpitaux et laboratoires. La collaboration étroite avec le centre national de référence affine la détection de nouveaux lignages et éclaire la compréhension des dynamiques épidémiques.
Quels impacts sur la santé publique, les vaccins et les mesures à venir ?
L’émergence de ces nouveaux variants SARS-CoV-2 influence directement les stratégies de santé publique. Les derniers indicateurs français révèlent une légère hausse des infections respiratoires liées à la COVID, sans augmentation nette des hospitalisations ou des décès à ce stade. Dans certains hôpitaux, quelques cas atypiques sont recensés, principalement chez des personnes vulnérables ou immunodéprimées. Ces signaux incitent à maintenir la vigilance, surtout dans les services à haut risque.
Concernant les vaccins COVID, les premières études montrent que les anticorps produits avec les formulations bivalentes conservent une efficacité jugée satisfaisante contre Nimbus. On observe néanmoins une diminution de la protection face aux formes symptomatiques, poussant les autorités à recommander des rappels ciblés pour les plus de 65 ans et les professionnels de santé. Un vaccin réajusté, intégrant les dernières mutations Spike, est à l’étude entre l’EMA et les industriels.
D’autres menaces infectieuses attirent aussi l’attention. Par exemple, le nombre de cas de Chikungunya progresse dans la région Pacifique occidental, d’où l’intérêt d’une surveillance renforcée, notamment pour les voyageurs de retour. Pour les épidémiologistes, tout repose sur le suivi rigoureux des données épidémiologiques et sur la capacité à adapter rapidement la réponse face à la moindre évolution du paysage viral.
De semaine en semaine, la liste des variants s’étire, les consignes évoluent, la surveillance se densifie. La vigilance ne faiblit pas. La science et les systèmes de santé restent sur le qui-vive, tandis que le virus, insaisissable, continue de défier les certitudes.







